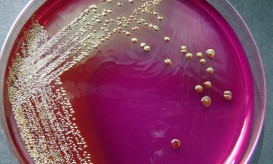
E.coli

Χιού Χέφνερ: Τα πάντα για το βακτήριο που οδήγησε στην καρδιακή ανακοπή – Συμπτώματα, αίτια, θεραπεία [vid]
Η λοίμωξη που οδήγησε στον θάνατο του Χιού Χέφνερ προκλήθηκε από το E.coli, ένα κοινό βακτηρίδιο που συχνά επιβιώνει...

Η λοίμωξη που οδήγησε στον θάνατο του Χιού Χέφνερ προκλήθηκε από το E.coli, ένα κοινό βακτηρίδιο που συχνά επιβιώνει...

Η διάρροια είναι μια αύξηση στη συχνότητα των κινήσεων του εντέρου ή μία πιο χαλαρή σύσταση ή υδαρή των...
Το γνωστό κολοβακτηρίδιο «Escherichia coli» (E.coli) γίνεται ολοένα πιο διάσημο, καθώς, όπως ανακοίνωσαν αμερικανοί βιολόγοι, είναι πλέον ο μικροοργανισμός...

Ετοιμάζεστε για τις καλοκαιρινές σας διακοπές; Ή μήπως μια ακόμα “εξόρμηση” στην κοντινή παραλία εκεί κοντά που κατοικείτε; Όπως...

Το Ε. coli αποτελεί gram αρνητικό βακτηρίδιο, που περιλαμβάνει πολλά διαφορετικά στελέχη τα οποία διαιρούνται σε δύο κατηγορίες: Αυτά...

Με τον όρο ουρολοίμωξη εννούμε μολύνσεις και λοιμώξεις του ουροποιητικού συστήματος από μικροοργανισμούς, όπως είναι τα βακτήρια, οι ιοί...

Ο ανθρώπινος οργανισμός είναι μια σχεδόν τέλεια μηχανή, την οποία μελετάμε εδώ και αιώνες και παρόλα αυτά εξακολουθεί να...

Ανθεκτικά στα αντιβιοτικά, μικρόβια που οι γιατροί χαρακτηρίζουν σαν “υπερ – μικρόβια” και τα οποία μέχρι πριν λίγο καιρό...

Μπορεί οι καταναλωτές να πληρώνουν το κάτι παραπάνω προκειμένου να αγοράσουν και να φάνε βιολογικό κρέας, που θεωρητικά είναι...

Η διατροφική επιδημία ,έχει άμεση σχέση με την E.Coli, που βρίσκετε στις καλλιέργειες εδάφους των πατατών και πράσων.Τι όμως...